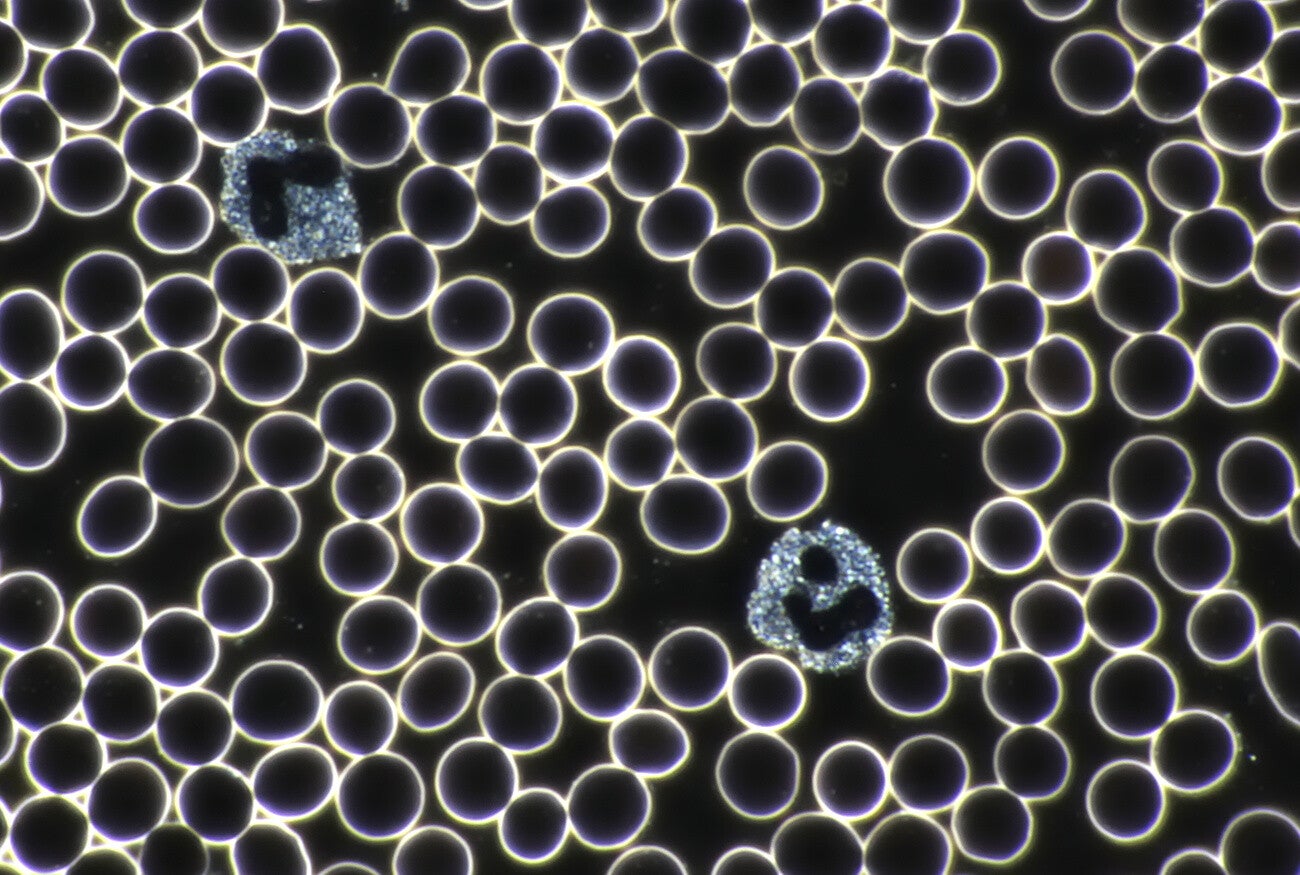

Welkom
In mijn praktijk draait het om jouw Wel-Zijn. Hoe zit jij in je vel? Samen gaan we in op je fysieke en mentale welzijn. Op dieper niveau kijken we naar jouw Wel-Zijn. Het (wel) aanwezig zijn. Ik ben aanwezig in mijn lijf. Ik leef mijn leven.
Over mij
Ik ben Lisanne, geboren en getogen in Heerenveen in het mooie Fryslân. Nuchtere noordeling met een groot hart.
Ik word heel gelukkig van mensen werkelijk kunnen helpen met hun gezondheid. Dit vergt een blik die verder kijkt, en een werkwijze die dieper gaat. Mijn reis op het holistische pad begon 7 jaar geleden toen ik startte met de opleiding tot Life Science Therapeut. Wauw! Mijn hart ging sneller kloppen van alle wijsheid en technieken die ik daar leerde!
Hierna heb ik me verdiept in orthomoleculaire therapie en sinds 2026 ben ik gespecialiseerd als NEI therapeut.
Ik werk met veel plezier en nieuwsgierigheid. Elke sessie is een avontuur waarin waardevolle inzichten zich laten zien.

Holistische aanpak
Wanneer jij bij mij komt met je hulpvraag of klacht dan doe ik eerst een anamnese. Wat houdt de klacht in en wat is je geschiedenis met de klacht? Waar zit voor jou het pijnpunt? En… Wat is jouw wens?
Daarna doe ik een radio intuïtieve test met de biotensor en kijk van waaruit we mogen starten. Mogelijke richtingen zijn:
NEI-therapie
In een NEI-sessie kijken we naar de emoties en blokkades die aan de klacht verbonden zijn. Nu, en in het verleden. Bewust en onbewust. Met behulp van de biotensor sporen we de emoties op en koppelen deze los. Hierdoor ontstaat RUIMTE.
NEI is geen praatsessie, maar een fijne en zachte, en effectieve manier om te kijken naar de oorzaak van de klacht. Vanuit daar kan verbetering plaatsvinden.
Lichamelijk welzijn
My body is my temple! We kijken naar de biochemie van jouw lichaam. Welke lichaamsprocessen en organen kunnen ondersteuning gebruiken?
Ik check je organen, bloed en vitamine-mineralenbalans. Vanuit hier kijk ik wat nodig is om het lichaam in balans te brengen. Dit kan een supplement zijn, of ik zet frequentietherapie in. Dit kan zeer helpend zijn bij (onbegrepen) klachten. Door gericht te werken kun je je weer fit en energiek voelen.
Ik werk vanuit een holistische visie. Een fysieke klacht hoeft niet alleen fysiek te worden behandeld. Door te kijken naar jou als mens, met alle bagage die je hebt, gaan we naar de wortel van het probleem en werken we vanuit daar aan herstel.
Om een traject volledig af te kunnen ronden zijn meestal 2 tot 3 sessies nodig. Bij een kleine hulpvraag volstaat soms 1 sessie al!
Hulpvraag
Met welke klacht of hulpvraag kun je bij mij terecht?
- Allergieën. Denk bijvoorbeeld aan hooikoorts of koemelkallergie.
- Huidklachten (overgevoeligheid, eczeem, gordelroos)
- Darmklachten
- Onbegrepen chronische klachten
- Belasting door parasiet, bacterie, schimmel of virus
- Vaccinatie ontstoren
- Stress, angst, depressie, faalangst
- Moe!
- Hormonen en vrouwelijke cyclus
- Kinderwens en zwangerschap
- Geboorte of bevallingstrauma
- Het gevoel iets te missen, altijd op zoek te zijn.
- Bijna elke klacht kan met behulp van NEI onderzocht, begrepen en verlicht worden.
Kinderen
NEI therapie is heel effectief bij kinderen. Afhankelijk van de leeftijd komt je kind wel- of niet mee naar de praktijk. Ik kan ook op afstand behandelen.
- Als je baby veel huilt kunnen we samen kijken wat daarachter schuilt.
- Wanneer je kind niet goed kan of wil slapen.
- Als je kind vaak ziek is.
- Als je kind spanningen ervaart.
- Wanneer je kind vastloopt op welk gebied dan ook.
- Verlichting op onderwijs gerelateerde dingen als dyslexie en dyscalculie.

Aanbod

NEI therapie
Laat je begeleiden in het vinden van jouw innerlijke kracht en balans. Onze coaching richt zich op persoonlijke groei, stressreductie en het creëren van een gezonde levensstijl, specifiek afgestemd op jouw doelen.

Systemisch werk
Soms komt in een NEI-sessie naar voren dat er iets zichtbaar mag worden in het (familie)systeem. Een bijzondere ervaring.
We doen een tafelopstelling met houten poppetjes en symbolen. Door ze in de positie te zetten die bij jouw situatie past, kan er veel inzichtelijk worden. Is er een disbalans? Waar zit deze? Wat gebeurt er als we een poppetje verschuiven?
Door in de tafelopstelling dingen te benoemen, doorvoelen en verschuiven, kan er in jouw eigen systeem ook een verschuiving plaatsvinden.

Vitaminen en mineralen balans
Vitaminen en mineralen zijn betrokken bij heel veel biochemische processen in het lichaam. Wanneer er een tekort is aan een bepaalde vitamine of mineraal, dan kunnen veel processen die hieraan gelinkt zijn niet goed plaatsvinden. Dit werkt als een domino-effect. Uiteenlopende klachten zijn gelinkt aan een tekort. Met de biotensor meet ik uit welke voedingsstof je behoefte aan hebt. Door deze aan te vullen kunnen vele processen weer plaatsvinden en ga je je beter voelen.
Levend Bloed Analyse
Soms is het waardevol om het bloed te bekijken en te analyseren, om te kijken naar de gesteldheid je bloed, wat aanwijzingen geeft voor de gesteldheid van je lichaam.
Ik bekijk het bloed onder een donkerveldmicroscoop. En wauw! Wat valt er veel te zien! Via het scherm kun je zelf meekijken.
”Dank je wel Lisanne! Na jouw sessie heb ik veel meer rust in mijn systeem gekregen waardoor ik meer energie heb. Ook de pijnklachten die ik had zijn zo goed als verdwenen”
Irene
Afspraak maken? Vul het formulier in en ik neem spoedig contact op.
Contactgegevens
Praktijk Wel-Zijn
Lisanne Fennema
Roerdomplaan 17
Heerenveen
email: info@praktijkwel-zijn.nl
bel of app: +31624517688


